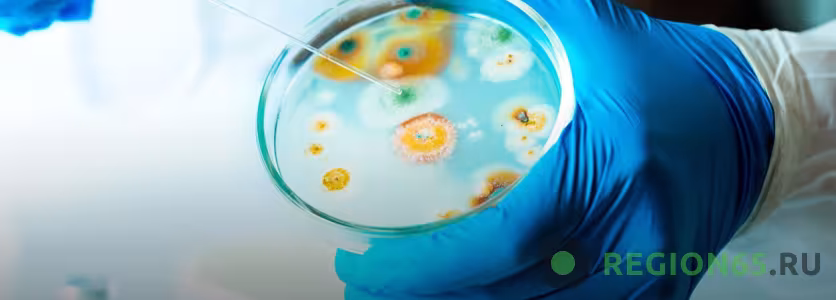

Новости
Московские ученые втрое увеличили выход метана из пищевых отходов
К микроорганизмам также применили особые методы стимуляции.
Специалисты Федерального научного агроинженерного центра ВИМ улучшили методику синтеза метана из пищевых отходов при помощи бактерий. Благодаря этому процесс ускорился, а выход полезного топливного газа увеличился втрое.
Обычно для синтеза используют один универсальный реактор. Специалисты разделили его на две связанные друг с другом установки: в одной бактерии перерабатывают пищевые отходы в газообразный водород и жидкие остатки, в другом из жидких остатков вырабатывают метан. Такой подход позволил создать для каждого процесса оптимальные условия, чтобы повысить эффективность.
В одном реакторе мы можем, управляя температурой, давлением и другими характеристиками среды, подавлять деятельность микроорганизмов, которые поглощают водород, и стимулировать те, которые его вырабатывают. В другом — стимулировать те, которые вырабатывают метан. За счет этого намного повышаются скорость реакции и выход целевого продукта. - рассказал главный научный сотрудник Федерального научного агроинженерного центра ВИМ Андрей Ковалев.
К микроорганизмам также применили особые методы стимуляции. Реактор для синтеза метана снабдили электродами, на которые подаются микротоки, увеличивающие скорость реакции. Дополнительно реакторы подогревают для создания внутри нужного микроклимата. При этом энергию «собирают» солнечными панелями. Их, отмечает Андрей Ковалев, можно использовать для обеспечения как электричеством всех вспомогательных систем: от датчиков до насосов, — так и теплотой. Так установка станет практически автономной.
Как показали испытания, по сравнению с классическими подходами выход водорода удалось увеличить в семь раз, метана — в три раза.
Комментарии
Комментариев по этой новости еще нет, будьте первыми!
Авторизация

